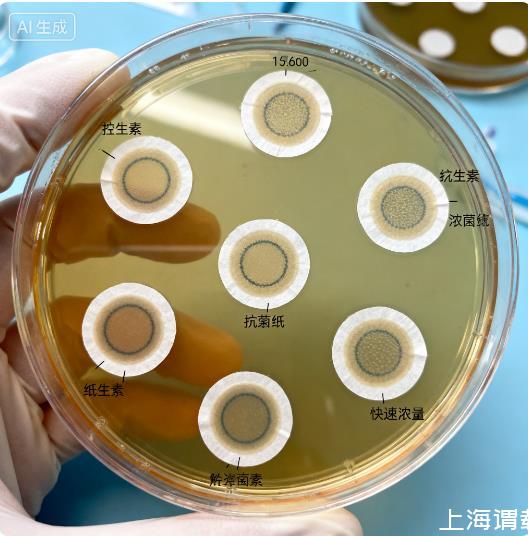

快速藥敏檢測技術方法、原理、臨床轉化需求(一)
1.3顯微自動聚焦技術與丹麥Biosense oCelloScope系統的技術融合
在傳統稀釋法藥敏試驗的基礎上,顯微自動聚焦技術通過高頻顯微拍攝(每小時進行動態監測),實時捕捉微生物在數量與形態上的變化,結合算法分析與數據庫比對,2~8小時內即可報告藥物的MIC值。目前,該技術已在陰性桿菌、葡萄球菌、腸球菌、鏈球菌等多種臨床常見細菌的藥敏檢測中表現出良好性能,相關驗證數據正在進一步完善中。
丹麥Biosense公司的微生物生長動態監測系統oCelloScope,正是基于“顯微自動聚焦+動態成像分析”的技術原理,實現了藥敏檢測的快速化與精準化,且在技術細節上進行了多項創新優化。該系統集成高分辨率光學成像模塊、恒溫孵育模塊與智能圖像分析系統,可在藥敏孵育過程中對微生物進行連續動態拍攝——每小時自動完成多次聚焦與成像,通過識別微生物形態(如細胞長度、寬度、團聚狀態)與數量的細微變化,早期判斷細菌是否被抗菌藥物抑制。
相較于傳統顯微自動聚焦技術,oCelloScope系統在以下方面實現了關鍵技術突破:
超高靈敏度成像能力:采用定制化光學鏡頭與高穩定性光源,可清晰捕捉單個細菌細胞的形態變化——即使在孵育2小時內,細菌數量未出現顯著增長時,也能通過細胞腫脹、分裂停滯、細胞膜完整性改變等細微形態特征,早期識別抗菌藥物的抑制作用,進一步縮短檢測時間;
全流程自動化與智能化:系統覆蓋從樣本加樣、恒溫孵育、動態成像到結果分析的全流程自動化操作,無需人工干預,有效減少人為操作誤差;內置的微生物形態數據庫涵蓋臨床常見致病菌(如大腸埃希菌、肺炎克雷伯菌、金黃色葡萄球菌、銅綠假單胞菌等),可通過AI算法自動比對不同藥物濃度下的微生物生長曲線,快速計算并輸出MIC值,降低對操作人員專業水平的要求;
廣譜臨床適用性:通過大量臨床驗證,該系統可適用于革蘭陰性桿菌、革蘭陽性球菌等多種臨床常見細菌的藥敏檢測,無需依賴專屬藥敏折點,可適配β內酰胺類、喹諾酮類、氨基糖苷類、大環內酯類等臨床常用抗菌藥物,有效解決了RAST方法適用范圍有限的問題;
臨床標本直接檢測能力:該系統支持對血培養陽性標本、尿液標本等臨床樣本的直接藥敏檢測,無需經過傳統的純培養步驟——例如,對血培養陽性標本的藥敏檢測可在4~6小時內完成,較傳統方法(24~48小時)縮短20小時以上,為重癥感染患者的緊急救治提供關鍵支持。
目前,oCelloScope系統已在多項臨床研究中驗證了其性能:針對肺炎克雷伯菌、銅綠假單胞菌等常見耐藥菌的藥敏檢測,其結果與微量肉湯稀釋法的基本一致性(EA)達到95%以上,分類一致性(CA)維持在85%~90%,且對碳青霉烯類耐藥菌(CRE)的檢測準確率顯著優于傳統方法[參考Biosense臨床驗證數據]。
二、基于熒光標記顯示細胞活性的快速藥敏技術
此類技術的核心原理是通過熒光物質標記微生物細胞的特定成分,利用熒光信號的變化反映細胞活性狀態,進而判斷抗菌藥物的抑制效果。其顯著優勢在于,可在微生物未形成肉眼可見生長前,通過熒光信號放大微生物活性的早期差異,實現藥敏結果的快速判讀。
2.1三磷酸腺苷(ATP)生物發光法
ATP是所有活細胞的核心能量載體,微生物細胞內的ATP含量相對穩定;熒光素酶可催化熒光素發生氧化反應并釋放生物光,而該反應的啟動必須以ATP為底物——當熒光素濃度足量時,反應產生的熒光強度與體系內游離ATP的含量呈正相關[13]。基于這一特性,ATP生物發光法可通過檢測熒光強度間接反映微生物活性,進而實現藥敏檢測。
國外學者最早將該技術應用于快速藥敏檢測,2小時內即可獲得MIC值,檢測限可達103CFU/mL,但該方法需先對微生物進行裂解以提取ATP,操作步驟較為復雜[14]。國內向杰等學者對該技術進行優化,省去ATP提取步驟,根據抗菌藥物作用機制的差異(將藥物分為生長依賴型/抑菌劑、致死依賴型/殺菌劑),設計不同的結果判斷標準。優化后的方法與微量肉湯稀釋法的檢測結果對比顯示,基本一致性(EA)達到90%,分類一致性(CA)為80%~84%,檢測周期從傳統的16~24小時縮短至5~6小時[15]。
此外,劉君等學者將該技術拓展至結核分枝桿菌藥敏檢測領域,通過優化孵育條件與檢測參數,可在(6.6±2.1)天內獲得藥敏結果,與傳統羅氏培養法的符合率達到95.2%,顯著縮短了結核分枝桿菌藥敏檢測的周期,為結核病的精準治療提供了支持[16]。
2.2熒光細胞染色法
該技術利用熒光染料的細胞膜滲透性差異,區分細菌的活性狀態:熒光染料SYBR GreenⅠ可穿透完整的細胞膜進入活細胞內,使活細胞呈現綠色熒光;碘化丙啶則無法穿透完整細胞膜,僅能進入細胞膜受損的死亡細胞或瀕死細胞,使這類細胞呈現紅色熒光。通過熒光顯微鏡或熒光分析儀檢測體系內綠/紅熒光的比值,即可量化細菌種群的存活狀態,進而判斷抗菌藥物的抑制效果。
Zhang等學者與Feng等學者分別基于該原理開發快速藥敏檢測方法,均實現了30~60分鐘內獲得快生長病原微生物藥敏結果的突破[1718],為臨床緊急感染救治提供了高效解決方案。
除上述雙色熒光染色法外,刃天青染色法也是常用技術路徑。刃天青作為一種氧化還原指示劑,在氧化狀態下呈藍色,在還原狀態下會不可逆地轉化為粉紅色熒光產物試鹵靈。細菌在生長繁殖過程中,細胞內處于還原環境,攝入細胞內的刃天青會被還原為試鹵靈并釋放至培養基中,導致培養基顏色從藍色變為粉紅色,且熒光強度與活性細胞數量呈正相關。基于這一特性,該方法最快可在2小時內獲得細菌藥敏結果[19]。但該技術存在一定局限性:刃天青無法被銅綠假單胞菌等非發酵革蘭陰性桿菌代謝,因此不適用于這類細菌的藥敏檢測,臨床應用范圍受限。為拓展應用場景,研究者開發基于刃天青還原法的微流體芯片技術,用于尿液中分離細菌的藥敏檢測,6小時內可獲得MIC值[20]。
2.3 qPCR檢測細菌16S rDNA
微生物與抗菌藥物共同孵育過程中,細胞代謝變化具有時間差異性:RNA與DNA的變化會在2小時內顯現,而蛋白質的變化則需4小時后才出現。考慮到RNA在體外易降解,難以保證檢測穩定性,使用通用引物檢測細菌16S rDNA(細菌核糖體RNA的編碼基因,具有物種特異性與高度保守性)更具臨床應用前景。
中國科學院武漢病毒研究所羅俊博士團隊基于這一思路,利用qPCR技術檢測與抗菌藥物共同孵育后的細菌16S rDNA,通過分析核酸拷貝數的變化判斷細菌生長抑制情況。在對36株銅綠假單胞菌和28株金黃色葡萄球菌的藥敏檢測中,該方法與標準微量肉湯稀釋法的結果一致性分別達到97.22%和96.43%[21],驗證了技術準確性。Xie等學者也通過類似技術路徑,在孵育2小時后成功檢測出鮑曼不動桿菌、肺炎克雷伯菌和金黃色葡萄球菌對不同抗菌藥物的敏感性[22],進一步證明了該技術的可行性。
三、基于細胞代謝狀態/產物檢測的快速藥敏技術
此類技術的核心邏輯是通過捕捉微生物代謝過程中的產物變化(如揮發性有機化合物、生物大分子合成情況),間接反映微生物的活性狀態,進而判斷抗菌藥物的抑制效果。其關鍵優勢在于利用高靈敏度檢測技術,放大代謝信號的早期差異,實現藥敏結果的快速判讀。
3.1代謝產物顯色法
細菌在生長繁殖過程中會釋放多種揮發性有機化合物,包括胺類、醛類、芳香族化合物、酮類、酯類等。基于這一特性,研究者設計了帶有化學小分子感受器的藥敏檢測孔——這些感受器可與細菌釋放的揮發性有機化合物發生特異性反應,導致顏色變化。檢測儀器每10分鐘對感受器顏色進行一次掃描,通過對比不同藥物濃度下感受器的顏色變化,可在早期區分有細菌生長與無細菌生長的藥敏孔,進而計算得出藥物的MIC值。
Antonelli等學者基于該技術搭建檢測平臺,直接對革蘭陰性桿菌血培養肉湯進行藥敏檢測,平均獲得藥敏結果的時間僅為4.6小時,較傳統方法縮短24~48小時[23]。該平臺還具有兩大優勢:一是血培養顯示陽性后16小時內的肉湯標本均可使用,無需嚴格控制標本采集時間;二是可檢測16~22種抗菌藥物,包括頭孢他啶/阿維巴坦、頭孢洛扎/他唑巴坦、美羅培南/韋博巴坦等新型抗菌藥物,為多重耐藥菌感染的精準治療提供了關鍵支持。
3.2拉曼光譜技術
拉曼散射是一種特殊的光散射現象:當光穿過介質時,極少數光子會與介質分子發生能量交換,導致散射光的頻率發生改變。通過光譜儀對散射光進行色散處理,并由探測器采集信號,可獲得拉曼光譜。分析拉曼光譜中峰的位置、漂移、寬度、強度等信息,可實現對樣品的定性與定量分析。目前,拉曼光譜技術已廣泛應用于生物化學、安檢安防、考古探測等多個領域。
在藥敏檢測領域,病原菌細胞內的核酸、蛋白質、脂質等生物大分子均可通過拉曼光譜呈現特征峰,且峰強度與分子在細胞內的含量呈正相關。當微生物受到抗菌藥物作用時,細胞內生物大分子的組成與代謝產物會發生改變,這些變化可通過拉曼光譜被精準捕捉,進而判斷抗菌藥物的效果——由于這類方法無需添加外源標記物,僅依賴微生物自身的光譜信號,因此被歸為拉曼藥敏技術的非標記檢測法[24]。
除非標記法外,標記法拉曼光譜技術是當前研究熱點,其中以重水(D?O)標記法最為成熟。該方法將D?O摻入藥敏培養基中,使其作為代謝標記物參與細菌的生物合成過程:重水中的氘原子會整合到細菌合成的蛋白質、脂質等生物大分子中,在拉曼光譜的“生物靜默區”(該區域無其他生物分子的光譜信號干擾)形成明顯的CD特征峰,且峰強度與細菌的代謝活性呈正相關[25]。
該技術的通用檢測步驟為:首先將細菌在含不同濃度抗菌藥物的培養基中孵育1~2小時;隨后向培養基中加入濃度為30%~100%的D?O,繼續孵育30分鐘左右;最后通過拉曼光譜儀檢測CD峰強度,根據峰強度判斷細菌的代謝活性,進而篩選出有效抗菌藥物[26]。
該技術具有三大核心優勢:一是無需對微生物進行培養、染色或其他標記處理,可直接檢測臨床標本;二是檢測速度快,對尿液標本的藥敏檢測僅需2.5小時,遠快于傳統方法(48小時);三是適用于無法培養或難培養的微生物(如某些厭氧菌、苛養菌)的藥敏檢測,為特殊感染性疾病的治療提供了新的技術路徑[27]。
